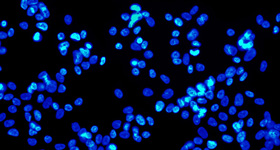

|
ある痩身サプリの
[権利獲得]について ご連絡が有ります |

| ダイエットの常識を覆す 世界の製薬業界では ※痩身ダイアモンド※ と称される ![]() 現在世界で最高クラス ダイエットモニターへの権利を |
|
▼世界20カ国以上で▼
![]() 肥満体型女性100人に 協力していただいた結果
大幅な減量を記録!! 証明された事実 |
||||
|
今回はそんな中でも
90キロオーバー肥満女性の 【痩 身 結 果 公 開】 |
▼わずか20日間で▼ ![]() 97.6kg⇒55.4kg 42.2kgの減量!! ▼わずか22日間で▼ ![]() 92.8kg⇒52.1kg 40.7kgの減量!! 本品は短期間での 大幅減量の可能性 があるため 痩せすぎる前に 飲用を中止して下サイ |

| 日本での使用に関して 公的機関の審査を受け受領された ![]() 本格減量の製品です そこらで買える ダイエット食品とは 区別が必要です ![]() |
| ※本製品は国内ではまだ厳しい検査の上で出荷となるため大量のモニター募集ができない状態です。次回入荷は完全未定となっておりますのでお早めにご購入ください。 |




| アメリカの抗肥満研究機関が 約7年に及ぶ 研究で発見!! ![]() 体内で痩身錠が脂肪を 燃 焼する際に輝くことで 海外のメディアでは ![]() 《ブルーダイヤモンド》 と発表されました 強制脂肪燃 焼信号を 体内に知らせる効果 普通の人は脂肪が消費される初動に約120分ほどかかるといわれています。
現在のあらゆるそして、痩せにくい人はこの脂肪消費動作に3時間以上の時間がかかるといわれています。 それをこのマジックダイアモンドブルーはたった10分で体内に特別な信号を送り脂肪燃 焼を強制的に開始させます!! 『痩身方法』で 唯一 飲むだけで身体に 《痩せる信号を送る》 【最終手段です】 |
| ※遺伝的肥満 ※体質的肥満 ※加齢による肥満 ※過食による肥満 ※運動不足による肥満 |

| 硬い脂肪の原因は リンパの流れの悪さが関係
リンパの流れが悪くなると、本来リンパから排 出されるはずの不要な老廃物が流れずに体内に滞ってしまい、どんどん蓄積されてしまいます。
溜まった老廃物は、脂肪にくっつきやすくどんどん付着していってしまうので、脂肪の周りは老廃物だらけになり、硬くなってしまうのです。 また、脂肪は何もせずに動かない状態でいると徐々に硬くなってしまう性質があり、あまり身体を動かさない人は、これも脂肪が硬くなってしまう原因とされています。 |
飲用期間 12日間 ![]() >>-19.2kg<< 飲用期間 10日間 ![]() >>体重-17.8kg<< みっともない ポッコリお腹も… 飲用期間 13日間 ![]() >>マイナス22.4cm<< |


![]() 成分を体内に投入すると… ↓ ↓ ↓ 5分後信号が伝わり ![]() 脂肪の燃 焼が始まり… ↓ ↓ ↓ 10分後には 身体がジンジンするほど ![]() 強力に脂 肪 燃 焼!! |
多い肥満女性でも ▼ ▼ ▼ 食事制限・運動ナシ!! 約1ヶ月で お腹周り-27.6cm!! ![]() ごまかせない CTスキャンで 確認してみると ▼ ▼ ▼ ![]() この通り脂肪が激減!! 脂肪吸引並みの 大幅ダウン!! |
| \モニター全員が/ 大幅痩身成功 |
| 石塚恵子様(33歳) 23日間飲用 |
![]() 92kg⇒57kg 【-39kgを記録】 |
| 本当に 驚きました。私の場合は3日目に急に体重が減り始めて、38%あった体脂肪率が1ヶ月で半分の19%に。20日を過ぎた頃には明らかに贅肉がなくなってき て使用頻度を減らしました!痩せる事を恐れたのは初めてです。でも体調が悪くなったりとかはないのでこれからも安心して飲めます! |
| 鈴本麻衣様(29歳) 14日間飲用 |
![]() 73kg⇒50kg 【-23kgを記録】 |
| 試験モニターに当選して使ってみたら初日から面白いくらい体脂肪と体重が落ちました。飲めば飲むほど落ちる。そんな印象を持ちました。他のサプリも使ってたんたけど別物ですね。ここ数年の最低体重記録を更新しました。ダイアモンドブルーすごい! |
| 柴崎和香奈様(24歳) 9日間飲用 |
![]() 65kg⇒50kg 【-15kgを記録】 |
| 飲んだ瞬間にわかりました。これは普通じゃないって!確かに体が熱くなるし、脂肪が燃 焼されている感じが体感できます!しかも体重も面白いように落ちる、落ちる!!次いつ購入できるかわかりませんが次回は大量購入しますw |
|
※厳重注意※
|
|
非常に危険なため
※※※※※※ 7日間で20kg以上 体重減少した場合 飲用を必ず中止してください。 ※※※※※※ |

|
これにより 食べたモノを 一切吸収せず ひたすら 燃やし続けるという ![]() かつてない 痩身力が実現!! |
|
減量成功率
96.7%を記録!! |
|
短期間で減量をしたくない方
痩せる意思がない方 ↑↑↑ 軽い気持ちでの申込みは 絶対にお止めください |

|
食事制限せずに体重や体脂肪を極限まで落とすコトを目的として研究された痩身剤です。
|

|
ある痩身サプリの
[権利獲得]について ご連絡が有ります |

| ダイエットの常識を覆す 世界の製薬業界では ※痩身ダイアモンド※ と称される ![]() 現在世界で最高クラス ダイエットモニターへの権利を |
|
▼世界20カ国以上で▼
![]() 肥満体型女性100人に 協力していただいた結果
大幅な減量を記録!! 証明された事実 |
||||
|
今回はそんな中でも
90キロオーバー肥満女性の 【痩 身 結 果 公 開】 |
▼わずか20日間で▼ ![]() 97.6kg⇒55.4kg 42.2kgの減量!! ▼わずか22日間で▼ ![]() 92.8kg⇒52.1kg 40.7kgの減量!! 本品は短期間での 大幅減量の可能性 があるため 痩せすぎる前に 飲用を中止して下サイ |

| 日本での使用に関して 公的機関の審査を受け受領された ![]() 本格減量の製品です そこらで買える ダイエット食品とは 区別が必要です ![]() |
| ※本製品は国内ではまだ厳しい検査の上で出荷となるため大量のモニター募集ができない状態です。次回入荷は完全未定となっておりますのでお早めにご購入ください。 |


|
※配送について |